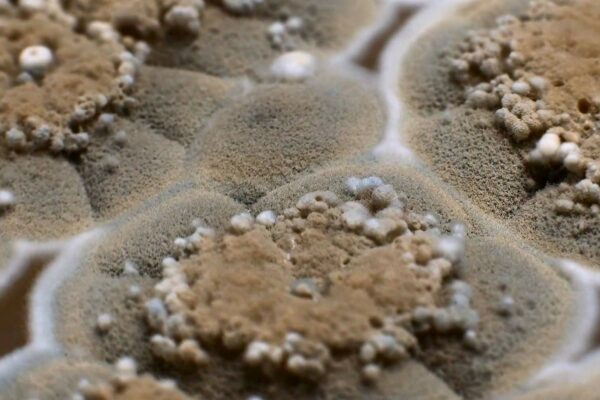
Mold – What you should know about it

Imagine that you have just settled into your dream house in Michigan: a comfortable basement, a well-equipped kitchen, and a nice yard. Everything feels right. What if something is lurking behind the floors and walls? You can neither see it, smell it, nor hear it. It is quietly raising the chances of major illnesses in your family. That danger is radon, and unless you do radon testing, you’d never know.
In the case of a house purchase in Michigan, it is necessary to know whether radon levels are high or low. It is a life-saving measure. This blog will help you understand why radon testing matters, what the real risks are in Michigan, and how you can make smart, informed decisions before you sign any document.
What is Radon, and Why Do Michigan Buyers Must Know About it
Radon is a naturally occurring radioactive gas produced by the degradation of uranium in soil and rocks. You can’t smell, taste, or see it.
In a home located on uranium-contaminated soil, radon may leak through cracks in walls, around pipes, in crawl spaces, or in cellars and accumulate indoors.
Radon is a human carcinogen. The prolonged contact with the intensified radon level poses a significant risk of lung cancer. Radon is the second most common cause of lung cancer in the United States, second to smoking.
Radon is not very common or concentrated in isolated locations in Michigan, in particular. Households with indoor radon concentrations exceeding the federal action level (4 picocuries per liter, or pCi/L) were estimated to be more than one in every four homes statewide.
Concisely, when you buy a house in Michigan, the air that you breathe may be contaminated. Radon testing is the only way to know for sure.
Is Radon Testing Necessary When Buying a Home
Because radon is invisible and unpredictable, radon testing is the only way to discover its presence. You cannot afford to be fooled by appearance, no matter how modern, new, or stylish a home is.
A “low-radon-risk neighborhood” displayed on the map does not mean that it is safe. The concentration of radon can vary significantly, even in adjacent areas, due to differences in soil composition, foundation condition, home orientation, and air circulation.
That’s why a short answer to “Is radon testing necessary?” is a resounding yes.
If you skip radon testing when buying, you could end up living for years in a house that silently puts your family’s health at risk.
What Radon Testing Looks Like, and What to Expect
Here’s how radon testing typically works in Michigan when you’re buying a home:
- Use a radon test kit or contract with a certified radon-testing professional. The Michigan Department of Environment, Great Lakes, and Energy (EGLE) provides information on testing and mitigation.
- The tests are most accurate during the heating season (winter), when it is not possible to open a window and air circulation is minimal.
- If the test indicates radon levels of 4 pCi/L or higher, which is the standard action level set by the U.S. Environmental Protection Agency (EPA), mitigation is highly advisable.
- Mitigation Systems are available to remove radon using radon ventilation systems that remove it at high levels, leaving the house safe.
- The cost of testing is very cheap and easy. Considering the severity of a health risk, it is a small step with a big reward.
Real Michigan Statistics
- EGLE estimates that one-in-four Michigan households have radon levels above the EPA-recommended level.
- It has been reported that all 83 Michigan counties have elevated radon levels; therefore, no area is considered safe by default.
- The gas has been known to kill a significant number of people (21,000) with cancer. The second most common environment-induced cause of cancer in the U.S., after smoking, is radon.
- A real-life case: in some counties in the north of Michigan, test results in local health department reports were as high as 20 pCi/L or more, or much higher than the safety level.
It demonstrates the degree of radon level fluctuation. Your neighbor’s house may be all right, but yours may be extremely high.
What Buyers Should Do Before They Sign
If you are house-hunting in Michigan, or you are planning to buy:
- Always include radon testing on your home inspection checklist.
- The test should be performed on an approved tester or a dependable test kit, preferably in winter or in a closed house.
- If the test is 4 pCi/L, negotiate a mitigation request with the seller to install a radon mitigation system, or change your offer to include the cost of radon mitigation.
If the radon level is low but still over 2 pCi/L, mitigation is worthwhile; foundation settling, changes in humidity, and airflow levels can affect radon levels in the future.
When you buy a home, it is advisable to have a radon test after a few years, or when you remodel, complete the basement, or alter the structure.
Conclusion
Purchasing a house in Michigan is a huge investment, both emotionally, economically, and as far as the security of your family is concerned. Yet here is a hidden health risk with serious long-term effects that many buyers may ignore. Radon, invisible, silent, and dangerous, might be lurking underground.
Radon testing isn’t a luxury or an option. It’s a necessary step if you’re serious about ensuring your home is safe. For a few dollars and a little effort, you can know whether your new home is a health hazard or a safe place.
Don’t let your dream Michigan home become a life threat.
If you’re ready to make sure your home is safe, schedule a professional inspection with Total House Inspection today. We’ll include thorough radon testing, explain the results clearly, and help you take action if needed. Protect your health and your family, don’t skip this critical step.